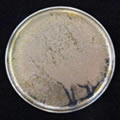
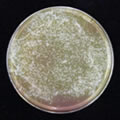
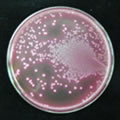

株式会社リンクス | 器具機材の殺菌 > FK-3 : ヘアケア用品、シャンプー・トリートメント、ヘアアイロン、化粧品、サプリメントなどのOEM・卸・商品開発
FK-3 |
食品に「やさしく」、そして「豪快な」殺菌力!
あらゆる食品の殺菌に
~惣菜用アルコール製剤(食品添加物)~

アルコールと塩素酸化物の二つの殺菌効果を同時に合せ持つことが可能となり、ほぼ全ての細菌類に対し低濃度で殺菌力を得ることができます。
[成分]
・主剤:エタノール 43.00%
・副剤:グリセリン 3.00%
・高度サラシ粉 3.00%
・副剤:キラヤサポニン 1.00%
食品素材 50.00%
[急性経口毒性試験]
LD50値2.000mg/kg(OECD402法)
[エタノール濃度]
50%v/v
[使用基準]
なし
[食品への添加物表示例]
酒精(またはアルコール)
ただし、加工工程中で食品の表面殺菌に噴霧した程度の場合や食品に浸透させない程度の浸漬で、最終食品への残存料が微量である場合加工助剤とみなされ、表示が不要となります。
[品質保証期間]
製造時より90日間
[荷 姿]
20kg入り バックインザボックス
本品は、一般的な加工食品の初発菌数に、非常に多く見受けられます、グラム陰性菌の中の大腸菌群等の低減に、効果的に作用するだけでなく、発酵食品等のように、真菌類(カビ、酵母)にまつわる腐敗が多く発生いたします加工食品類の原料処理剤と致しましても、十分な効果を発揮致します。
発酵食品類は、その製品の特性上、比較的、長い賞味期限を設定されておられ、どのメーカー様でもグラム陽性菌である乳酸菌類の増殖抑制対策は施されておられるようではありますが、真菌類の増殖抑制対策は、あまり講じておられないと言うのが実状のようであります。このことから、この真菌類の増殖が原因となり、調味の泥状現象、白斑の発生、膨張現象、へこみ現象などの外面的な問題、並びに、異臭を伴うなどの官能的な問題等によりまして、製品類の腐敗を招き、クレームにつながってしまいます。また、塩蔵や乾燥品を原料として使用致しました製品類にも、このような現象は多く見られ、穏慢な塩締めや、水分活性が1.0に近い状態での保管は微生物類の増殖を招くばかりではなく、このような原料を使用する加工食品類は、脱塩処理とともに、一斉に微生物類が増殖し始めてまいります。
そこで、これらの微生物類を、予め、本品「FK-3」にて、殺菌処理を施しておくことによりまして、発酵作用の妨げとなります細菌類を減菌させておくことができ、静菌剤に頼らずとも安定した賞味期限を確保しておくことが可能となります。また、これらの腐敗微生物類が、引き起こしてしまいます外観や官能的変敗によりまして、製品類に弊害を与える場合の対策方法と致しまして、本品の開発コンセプトであります、アルコールと高度サラシ粉製剤によります殺菌効果を発揮することができ、クレーム対策や、賞味期限の延長にお役立ていただけるものと考えております。
但し、鮮魚介類には、あらゆる食品添加物の使用は禁止されておりますことから、決して、使用しないで下さい。
本品で5.0%~10.0%の水溶液を作成していただき、原料を6時間~24時間内程度の浸漬処理を行ってください。また、本品の50%~原液によります洗浄、噴霧、混合、撹拌時でのご使用も効果的であります。
『FK-3』と『75%アルコール』の「サルモネラ菌」、「黄色ブドウ球菌」、「大腸菌」に対する効力
食中毒の原因となります「サルモネラ菌」、「黄色ブドウ球菌」、「大腸菌」に対しまして、一般的な『75%アルコール(W/W)』と『FK-3』を使用した場合の耐性力テストを行いました。
試験内容
● 殺菌剤の調整
108菌に各薬剤を規定濃度になるように混釈し反応させた。
● 菌液の塗布
DHL寒天培地または卵黄加マンニット食塩寒天培地に、薬剤と反応させた菌液をコンラージ棒で塗布した。
● 培養時間
サルモネラ菌、黄色ブドウ球菌:37℃ 48時間
大腸菌:37℃ 24時間

Control |

0.4%(250倍希釈) |

2.0%(50倍希釈) |

4.0%(25倍希釈) |

Control |
1.0%(100倍希釈) |

5.0%(20倍希釈) |

10.0%(10倍希釈) |

Control |

0.4%(250倍希釈) |

2.0%(50倍希釈) |

4.0%(25倍希釈) |
Control |

1.0%(100倍希釈) |

5.0%(20倍希釈) |

10.0%(10倍希釈) |

Control |

0.4%(250倍希釈) |

2.0%(50倍希釈) |

4.0%(25倍希釈) |

Control |

1.0%(100倍希釈) |

5.0%(20倍希釈) |
10.0%(10倍希釈) |